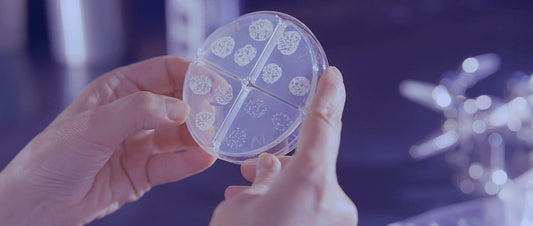
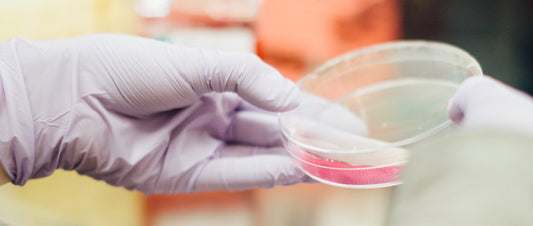

mybacs

Come si compone il prezzo dei nostri prodotti?
Con questo articolo vogliamo far fede al principio di trasparenza al quale teniamo molto ed andremo a spiegare quali sono i fattori che influenzano il prezzo del nostro prodotto. Noi...
Come si compone il prezzo dei nostri prodotti?
Con questo articolo vogliamo far fede al principio di trasparenza al quale teniamo molto ed andremo a spiegare quali sono i fattori che influenzano il prezzo del nostro prodotto. Noi...

Probiotici, prebiotici e simbiotici- Tutto ciò ...
1. Perché assumere probiotici L'intestino è il motore della nostra salute e le sue funzioni vanno ben oltre la digestione degli alimenti. Quindi, se il nostro intestino non si trova in...
Probiotici, prebiotici e simbiotici- Tutto ciò ...
1. Perché assumere probiotici L'intestino è il motore della nostra salute e le sue funzioni vanno ben oltre la digestione degli alimenti. Quindi, se il nostro intestino non si trova in...
I ceppi di batteri che fanno bene alla salute
In questo articolo vogliamo presentarvi alcuni dei più importanti ceppi batterici presenti all'interno del nostro Dailybacs. 1. I bifidobatteri: I bifidobatteri sono tra i probiotici più abbondanti all'interno del corpo umano: costituiscono oltre...
I ceppi di batteri che fanno bene alla salute
In questo articolo vogliamo presentarvi alcuni dei più importanti ceppi batterici presenti all'interno del nostro Dailybacs. 1. I bifidobatteri: I bifidobatteri sono tra i probiotici più abbondanti all'interno del corpo umano: costituiscono oltre...
Ceppi batterici residenti e transitori
Il termine "residente" deriva dal latino e significa "stabilirsi". I batteri residenti sono quindi microrganismi che si sono stabiliti stabilmente nel microbioma per un lungo periodo di tempo. Si sono...
Ceppi batterici residenti e transitori
Il termine "residente" deriva dal latino e significa "stabilirsi". I batteri residenti sono quindi microrganismi che si sono stabiliti stabilmente nel microbioma per un lungo periodo di tempo. Si sono...

Il microbiota cutaneo: la nostra barriera prote...
Il microbiota cutaneo: cosa c'è da sapere e come mantenerlo in equilibrio Sapevate che il vostro corpo ospita più di 38 trilioni di microrganismi? Ciò significa che i batteri costituiscono...
Il microbiota cutaneo: la nostra barriera prote...
Il microbiota cutaneo: cosa c'è da sapere e come mantenerlo in equilibrio Sapevate che il vostro corpo ospita più di 38 trilioni di microrganismi? Ciò significa che i batteri costituiscono...

L'asse intestino-cervello
L'asse intestino-cervello: dal CERVELLO al GUTT, dal GUTT al CERVELLO Se non avete nulla nella testa, non avete nulla nell'intestino. Probabilmente starete pensando: cosa c'entrano queste due cose? Ma questa...
L'asse intestino-cervello
L'asse intestino-cervello: dal CERVELLO al GUTT, dal GUTT al CERVELLO Se non avete nulla nella testa, non avete nulla nell'intestino. Probabilmente starete pensando: cosa c'entrano queste due cose? Ma questa...